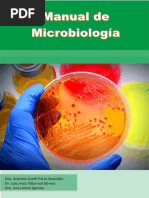

0% encontró este documento útil (0 votos)
85 vistas16 páginasPráctica de Microscopia en Microbiología
Este documento describe una práctica de laboratorio sobre el uso del microscopio. Explica las partes principales de un microscopio óptico como el objetivo, ocular y platina. Detalla los pasos para el manejo correcto del microscopio incluyendo cómo colocar la muestra, enfocar y cambiar entre objetivos. El documento enfatiza la importancia de la limpieza y seguridad al usar el microscopio.
Cargado por
fabiola nikolDerechos de autor
© © All Rights Reserved
Nos tomamos en serio los derechos de los contenidos. Si sospechas que se trata de tu contenido, reclámalo aquí.
Formatos disponibles
Descarga como PDF, TXT o lee en línea desde Scribd
0% encontró este documento útil (0 votos)
85 vistas16 páginasPráctica de Microscopia en Microbiología
Este documento describe una práctica de laboratorio sobre el uso del microscopio. Explica las partes principales de un microscopio óptico como el objetivo, ocular y platina. Detalla los pasos para el manejo correcto del microscopio incluyendo cómo colocar la muestra, enfocar y cambiar entre objetivos. El documento enfatiza la importancia de la limpieza y seguridad al usar el microscopio.
Cargado por
fabiola nikolDerechos de autor
© © All Rights Reserved
Nos tomamos en serio los derechos de los contenidos. Si sospechas que se trata de tu contenido, reclámalo aquí.
Formatos disponibles
Descarga como PDF, TXT o lee en línea desde Scribd